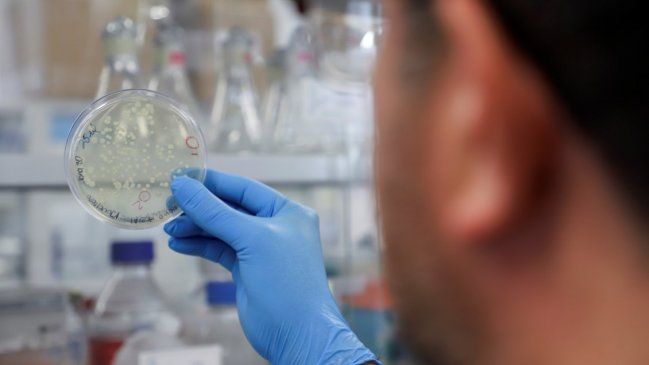

El rector de la Universidad de Chile, Ennio Vivaldi, entregó hoy detalles respecto al convenio que se firmó hace algunos días con sus pares de las Universidades de Antofagasta y Católica, una iniciativa que tiene como objetivo potenciar la creación de una red de centros de investigación y desarrollo para la elaboración de vacunas.
"Quisiéramos que además de lo que estamos apoyando en Antofagasta que nos parece muy importante, haya un centro en el cual se den todas las fases de producción y exportación", manifestó Vivaldi a EmolTV.
"Nosotros hemos ofrecido el espacio de Laguna Carén, porque creemos haber tenido mucho éxito al impulsar otros proyectos con universidades, el Estado y también privados", añadió.
De igual manera, Vivaldi enfatizó que no tener un lugar disponible para la investigación y desarrollo de vacunas en el país, tiene graves efectos en cuanto a su autonomía y soberanía.
"No podemos depender de nadie para algo tan importante como producir vacunas para nuestra población y también destacar, es que es muy importante tener una comunidad científica muy sólida", señaló.
REUNIONES CON PRODUCTORES DE LA REGIÓN Y EMPRESARIOS EUROPEOS
En esa mísma línea, equipos de la Universidad de Chile concretaron conversaciones con centros productores e industriales como la Asociación de Laboratorios Farmacéuticos (Asilfa) en Chile y de otros países como Argentina o Brasil; y también con grupos universitarios y empresariales europeos, específicamente de Alemania e Italia.
Respecto de los plazos para la implementación de esta iniciativa, Vivaldi indicó que "pensamos que de tener éxito nuestras gestiones creo que una cosa totalmente instalada tomaría entre 3 a 4 años, pero tener frutos concretos con productos concretos podría ser en un plazo muy anterior a ese".
Finalmente, el rector agregó que "Chile tiene todo para ser un protagonista más. El tema es cómo uno se sienta en las mesas, cómo es visto por los demás y cómo interactúa con los demás. Y, cuando lanzamos la idea de volver a tener un centro de vacunas, la cantidad de contactos que hemos tenido de distintas instancias, y países ha sido impresionante. Estamos muy optimistas de que podemos andar muy bien".